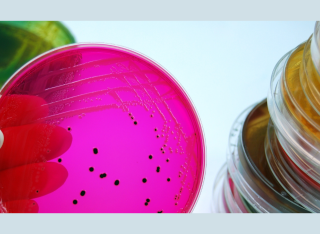
Image of Salmonella on petri dish, Getty Images

Dr Gianni Lo Iacono
About
Biography
Gianni is a theoretical physicist specialized in fluid dynamics with an initial background in particle physics. After his PhD at the University of Warwick he started to work at Silsoe Research Institute and then Rothamsted (two agricultural research institutes) studying the motion of aerosols in turbulent flows, searching strategy of insects and epidemiology of plant disease (evolution of pathogens in response to crop resistance).
Then he moved to the Veterinary School at the University of Cambridge working on vector borne diseases and zoonotic diseases. He then spent a few years in Public Health England focusing on the link between environmental changes and infectious diseases. In September 2017 he joined the School of Veterinary Medicine as lecturer in Biostatistics and Epidemiology.
Some measures of esteem
Several papers of mine have been cited in many policy documents, including documents from the WHO, CDC and the recent Sixth Assessment Report (AR6) of the United Nations.
My academic outputs have been cited multiple times in journals of exceptional level like including Nature, The New England Journal of Medicine, The Lancet. The Lancet Infectious Diseases, Cell, Nature Communication, Nature Climate Change, PNAS.
I act as expert reviewer for many journals including: Nature Communication, Nature Climate Change, The Lancet Infectious Disease, The Lancet Global Health, The Lancet Planetary Health and Ecology Letters.
Affiliations and memberships
Get in touch
Feel free to contact me if you are interested in a PhD in epidemiology\mathematical modelling.
Please, bear in mind that this type of research requires strong quantitative skills as well as relevant biological knowledge.
News
In the media
ResearchResearch interests
My initial research focused on modelling motion of aerosols and odour concentration in turbulent flows.
After that I moved to theoretical epidemiology modelling evolution of plant pathogens in response to crop resistance. Then I started working on animal and human diseases, developing models to disentangle different mode of transmissions (human-to-human from rodent-to-human for Lassa fever) and to assess the impact of weather and/or climate on midge-borne diseases and water-borne diseases.
My current research mainly focuses on modelling the impact of environment on infectious diseases with special interest on vector-borne diseases like Rift Valley fever and gastro-intestinal diseases like campylobacteriosis and salmonellosis. I have also a strong interest in studying the dynamics of microbial communities and patterns of animal movement.
Research projects
Investigating the chronobiology of healthy household dogs, canine osteoarthritis, cognitive dysfunction and pruritusPhD project (Completed)
Funder Zoetis.
PhD Student: Emma Theobald
This research investigates the diurnal rhythms of household dogs with various health conditions, as measured by PetDialog+ device. PetDialog+ is a small and light-weight, collar worn accelerometer device that can detect eight behavioural states of a dog, such as different gaits, eating, drinking and sleep, through measuring the movement of the dogs.
PhD project.
Funders: EU (OneHealth EjP) and Zoetis.
PhD Student: Laura Gonzales Villeta
Our goal is to develop a tool to assess the public health risk of foodborne zoonosis based on information of relevant environmental factors. Accordingly, we are interested in the following over-arching questions:
- Can we identify the key environmental processes triggering and propagating foodborne zoonoses?
- Can we disentangle the role of animal, human (including socio-economic factors) and environmental factors in foodborne zoonoses?
- Can we identify the delay between variations in the environment (e.g. increase in the temperature or behavioural change) and the occurrence of a foodborne outbreak?
- How can we quantify their impact on Public Health?
We will focus on Salmonella, for which the mechanism of transmission is relatively well known (e.g. effects of temperature and water activity), which will help in validating our approach.
The role of free extracellular DNA in dissemination of antimicrobial resistance over ecosystem boundaries along the food/feed chain.This project is a Work Package of FED-AMR
Funder: EU (OneHealth EjP)
PostDoc Researcher: Dr Brian Gardner
In this project we are developing probabilistic and mechanistic models explaining the links between antimicrobial usage in animals, AMR in the environment, and the risks for public health
PhD Project
Funder: This PhD studentship has been generously funded by the Longhurst Legacy
PhD student: Sophie North
Mosquitoes are considered the deadliest animal in the world because of the devastating diseases that they carry. These include Rift Valley fever, whose outbreaks can lead to large economic losses to farmers, and sometimes hundreds of deaths in humans.
Many strategies to tackle mosquito-borne diseases have been proposed, for instance vaccination, change in water-body dynamics (due to, e.g. irrigation) and reduction of the mosquito population (via insecticides or releasing genetically modified, non-biting, male mosquitoes incapable of producing viable offspring). Mathematical models are powerful tools to safely assess these control strategies before applying them in the real world. These models need to capture the effects of weather/climate as mosquitoes thrive in warm and wet regions, to determine under which environmental conditions the mosquito population and/or the infection can fade out or establish.
In this project we will develop and use models to assess the efficacy of classical and novel (e.g. release of genetically modified mosquitoes) strategies and some of their combinations. The modelling work will be relevant/applicable to other widespread vector-borne diseases.
Research collaborations
Research in Zoonotic Diseases
Dynamic Drivers of Disease in Africa (DDDAC) (Finished)
Research in salmonellosis
This project is part of the the One Health European Joint Programme. The One Health EjP is a landmark partnership between 44 partners, including acclaimed food, veterinary and medical laboratories and institutes across Europe and the Med-Vet-Net Association.
EnvDis is co-funded by Zoetis and in collaboration with Public Health England.
Collaborators:
Prof Gordon Nichols
Dr Theo Kanellos
Dr Catriona Fenton
Dr Emma Gillingham
Prof Alasdair Cook
Dr Joaquin Prada
Ms Laura Gonzales Villeta
Research in Mosquito borne Rift Valley fever
Dr Bernard Bett from International Livestock Research Institute, Nairobi, Kenya and
Dr Christophe Boëte from the Institut des Sciences de l'Evolution (ISEM), Université de Montpellier
Dr Martha Betson, University of Surrey
Research in Anti Microbial Resistance
This project is part of the the One Health European Joint Programme. The One Health EjP is a landmark partnership between 44 partners, including acclaimed food, veterinary and medical laboratories and institutes across Europe and the Med-Vet-Net Association.
The project involves a large number of collaborators that can be found here.
Research in Uncovering the link between the environment and environmentally driven gastro-intestinal disease.
Collaborators
Prof Dave Lloyd
Dr Stefan Klus
Dr Naratip Santitissadeekorn
Dr Christophe Sarran (Met Office)
Prof Gordon Nichols (PHE)
Former Member of PLOS ONE Editorial Board.
Research interests
My initial research focused on modelling motion of aerosols and odour concentration in turbulent flows.
After that I moved to theoretical epidemiology modelling evolution of plant pathogens in response to crop resistance. Then I started working on animal and human diseases, developing models to disentangle different mode of transmissions (human-to-human from rodent-to-human for Lassa fever) and to assess the impact of weather and/or climate on midge-borne diseases and water-borne diseases.
My current research mainly focuses on modelling the impact of environment on infectious diseases with special interest on vector-borne diseases like Rift Valley fever and gastro-intestinal diseases like campylobacteriosis and salmonellosis. I have also a strong interest in studying the dynamics of microbial communities and patterns of animal movement.
Research projects
PhD project (Completed)
Funder Zoetis.
PhD Student: Emma Theobald
This research investigates the diurnal rhythms of household dogs with various health conditions, as measured by PetDialog+ device. PetDialog+ is a small and light-weight, collar worn accelerometer device that can detect eight behavioural states of a dog, such as different gaits, eating, drinking and sleep, through measuring the movement of the dogs.
PhD project.
Funders: EU (OneHealth EjP) and Zoetis.
PhD Student: Laura Gonzales Villeta
Our goal is to develop a tool to assess the public health risk of foodborne zoonosis based on information of relevant environmental factors. Accordingly, we are interested in the following over-arching questions:
- Can we identify the key environmental processes triggering and propagating foodborne zoonoses?
- Can we disentangle the role of animal, human (including socio-economic factors) and environmental factors in foodborne zoonoses?
- Can we identify the delay between variations in the environment (e.g. increase in the temperature or behavioural change) and the occurrence of a foodborne outbreak?
- How can we quantify their impact on Public Health?
We will focus on Salmonella, for which the mechanism of transmission is relatively well known (e.g. effects of temperature and water activity), which will help in validating our approach.
This project is a Work Package of FED-AMR
Funder: EU (OneHealth EjP)
PostDoc Researcher: Dr Brian Gardner
In this project we are developing probabilistic and mechanistic models explaining the links between antimicrobial usage in animals, AMR in the environment, and the risks for public health
PhD Project
Funder: This PhD studentship has been generously funded by the Longhurst Legacy
PhD student: Sophie North
Mosquitoes are considered the deadliest animal in the world because of the devastating diseases that they carry. These include Rift Valley fever, whose outbreaks can lead to large economic losses to farmers, and sometimes hundreds of deaths in humans.
Many strategies to tackle mosquito-borne diseases have been proposed, for instance vaccination, change in water-body dynamics (due to, e.g. irrigation) and reduction of the mosquito population (via insecticides or releasing genetically modified, non-biting, male mosquitoes incapable of producing viable offspring). Mathematical models are powerful tools to safely assess these control strategies before applying them in the real world. These models need to capture the effects of weather/climate as mosquitoes thrive in warm and wet regions, to determine under which environmental conditions the mosquito population and/or the infection can fade out or establish.
In this project we will develop and use models to assess the efficacy of classical and novel (e.g. release of genetically modified mosquitoes) strategies and some of their combinations. The modelling work will be relevant/applicable to other widespread vector-borne diseases.
Research collaborations
Research in Zoonotic Diseases
Dynamic Drivers of Disease in Africa (DDDAC) (Finished)
Research in salmonellosis
This project is part of the the One Health European Joint Programme. The One Health EjP is a landmark partnership between 44 partners, including acclaimed food, veterinary and medical laboratories and institutes across Europe and the Med-Vet-Net Association.
EnvDis is co-funded by Zoetis and in collaboration with Public Health England.
Collaborators:
Prof Gordon Nichols
Dr Theo Kanellos
Dr Catriona Fenton
Dr Emma Gillingham
Prof Alasdair Cook
Dr Joaquin Prada
Ms Laura Gonzales Villeta
Research in Mosquito borne Rift Valley fever
Dr Bernard Bett from International Livestock Research Institute, Nairobi, Kenya and
Dr Christophe Boëte from the Institut des Sciences de l'Evolution (ISEM), Université de Montpellier
Dr Martha Betson, University of Surrey
Research in Anti Microbial Resistance
This project is part of the the One Health European Joint Programme. The One Health EjP is a landmark partnership between 44 partners, including acclaimed food, veterinary and medical laboratories and institutes across Europe and the Med-Vet-Net Association.
The project involves a large number of collaborators that can be found here.
Research in Uncovering the link between the environment and environmentally driven gastro-intestinal disease.
Collaborators
Prof Dave Lloyd
Dr Stefan Klus
Dr Naratip Santitissadeekorn
Dr Christophe Sarran (Met Office)
Prof Gordon Nichols (PHE)
Former Member of PLOS ONE Editorial Board.
Supervision
Postgraduate research supervision
Sophie North
Postgraduate research supervision
Jessica Furber (Co-Supervision)
Mahbod Entezami (Co-Supervision)
Isaac Ring (Co-Supervision)
Natasha Edwards (Co-Supervision)
Rhiannon Moody (Co-Supervision)
Teaching
- Module Coordinator: "Animal in Society II"
- "Hypothesis Testing" and "Interpretation of diagnostic tests". Module: Animal in Society II
- "Hypothesis Testing" and "Interpretation of diagnostic tests". Master Course
- Supervision of undergraduate Research Projects
- "Modelling". Module: Contemporary Issues In Veterinary Medicine.
Sustainable development goals
My research interests are related to the following:







Publications
Understanding animal movements at different spatial scales presents a significant challenge as their patterns can vary widely from daily foraging behaviours to broader migration or territorial movements. This challenge is of general interest because it impacts the ability to manage wildlife populations effectively. In this study, we conduct diffusion analysis based on European badger (Meles meles) movement data obtained from three different regions in the UK (Gloucestershire, Cornwall, and Northern Ireland) and fit a generalised linear mixed-effects model to examine the relationship between variables. We also feature a novel application of extended dynamic mode decomposition (EDMD) to uncover patterns relating to badger social organisation. By applying our approach to these different populations, we were able to assess its performance across a range of badger densities. A key result was that in some areas, EDMD clusters matched observed group home ranges, whilst in others, discrepancies likely arose because of population management interventions, such as badger culling. The methods presented offer a promising approach for studying territoriality and the impacts of management strategies on animal movement behaviour.
Gut microbiota are essential for maintaining host health, for example by providing protection against pathogens. This has prompted numerous studies to explore the composition and diversity of microbial communities using metagenomics techniques. Although this allows some degree of insight, there remains a shortcoming in understanding the interactions and temporal dynamics of these communities in greater detail. Moreover, this knowledge gap becomes further pronounced as we also consider the impact of external perturbations, for example antibiotic treatment, on the long-term stability of these microbial communities. To address this, we developed a mechanistic modelling framework based on the generalised Lotka–Volterra model to predict microbial compositional changes over time and to assess its sensitivity to applied external perturbation. Essentially, whether or not the microbial community bounces back to its original configuration once the perturbation has stopped. Using in-silico data and publicly available data derived from 16S rRNA sequencing, we estimated microbial growth rates and their mutual interactions. This model relies on absolute abundance counts, which can be estimated from total microbial biomass measurements, and the data is organised into the topmost abundant taxa organised at the genus level to prevent over-fitting. Bayesian inference was used to estimate model parameters from these abundance counts. Perturbations were represented by imposing seasonal changes in microbial growth rates that fluctuated about their non-perturbed values. After fitting the model to these datasets, we explored different applications of the perturbation signal and evaluated its impact on the long-term stability of the community dynamics. The model shows that, even if the intensity of the perturbation is the same (e.g., a given dosage of antibiotics), there are specific frequencies at which the perturbation is administered that can cause pronounced responses (resonance). Essentially, we can induce large deviations in microbial abundances from their equilibrium values and even drive some taxa to extinction. Applications of this approach include identifying optimal antibiotic treatment regimens to minimise the emergence of superbugs resistant to antibiotics and informing personalised strategies for maintaining a healthy gut microbiota.
Vector-borne diseases are a major global health concern, with Rift Valley fever (RVF) serving as a key example due to its impact on both human and animal health. Effective control and prediction of such diseases require an understanding of how environmental factors influence mosquito ecology. As mosquito abundance, distribution, and behavior are shaped by ecological conditions, identifying these drivers is essential for anticipating transmission risk and informing public health interventions. This study aims to assess the sensitivity of key factors governing the ecology of mosquitoes, using a deterministic, compartmental model developed for the transmission of RVFV in Kenya. Specifically, we investigate the influence of four model parameters on mosquito abundance, focusing on the proportion of water body area utilized for oviposition. A literature review was conducted to establish parameter ranges and distributions. The Sobol method of global sensitivity analysis was then applied to a simplified model environment, firstly with constant temperature and water body area and secondly with periodic temperature and water body area. The indices calculated were used to rank the parameters based on their influence on mosquito abundance. The analysis showed that there is a need to reduce uncertainty in the area scanned by Culex and identified the proportion of water body area used for oviposition as a highly influential parameter. This finding underscores the need for further research into spatial oviposition trends across different water bodies, as current literature lacks sufficient data to inform realistic parameter estimates.
Background: Antibiotic resistance increasingly threatens the interconnected health of humans, animals, and the environment. While misuse of antibiotics is a known driver, environmental factors also play a critical role. A balanced One Health approach—including the environmental sector—is necessary to understand the emergence and spread of resistance. Methods: We systematically searched English-language literature (1990–2021) in MEDLINE, Embase, and Web of Science, plus grey literature. Titles, abstracts, and keywords were screened, followed by full-text reviews using a structured codebook and dual-reviewer assessments. Results: Of 13,667 records screened, 738 met the inclusion criteria. Most studies focused on freshwater and terrestrial environments, particularly associated with wastewater or manure sources. Evidence of research has predominantly focused on Escherichia coli and Pseudomonas spp., with a concentration on ARGs conferring resistance to sulphonamides (sul1–3), tetracyclines (tet), and beta-lactams. Additionally, the People’s Republic of China has produced a third of the studies—twice that of the next country, the United States—and research was largely domestic, with closely linked author networks. Conclusion: Significant evidence gaps persist in understanding antibiotic resistance in non-built environments, particularly in marine, atmospheric, and non-agricultural set65 tings. Stressors such as climate change and microplastics remain notably under-explored. There is also an urgent need for more research in low-income regions, which face higher risks of antibiotic resistance, to support the development of targeted, evidence-based interventions.
Background Feline blood transfusion is required for the treatment of various illnesses in cats, and the safety of donor cats is vital. Donor adverse reactions can include cardiorespiratory, venepuncture-related, and behavioural abnormalities. Hypothesis/Objectives To describe a large number of feline blood donation events and document use of sedation and anxiolysis, record volume of blood collected and describe the frequency, type, and risk factors for, adverse reactions. Animals The study included 7812 individual cats and 29 201 donation events at a blood banking centre over 5 years. Methods Retrospective analysis of donation event records with signalment, donation volume, sedation status, donation number, and adverse reactions (acute and caregiver reported) recorded. Risk factors for adverse reactions were examined by stratifying data according to groups exposed to relevant predictors and calculating odds ratios with 95% and 99% confidence intervals (CIs). Results Adverse reactions were uncommon (0.29%, 2.88/1000 donor events) and most commonly were cardiorespiratory (0.08%, 0.75/1000 donor events) or behavioural (0.06%, 0.62/1000 donor events). The only risk factor significantly associated with adverse reactions was conscious donation, with conscious donors 4.4 times more likely to have an adverse reaction (95% CI, 2.5-7.9, P ≤ .0001). Conclusions and Clinical Importance Feline blood donation is associated with a low rate of adverse reactions. Sedation should be considered to reduce adverse reactions, and the environment and interactions optimized to reduce donor stress. Caregiver education on care post donation could reduce behavioural adverse reactions.
Disentangling the impact of the weather on transmission of infectious diseases is crucial for health protection, preparedness and prevention. Because weather factors are co-incidental and partly correlated, we have used geography to separate out the impact of individual weather parameters on other seasonal variables using campylobacteriosis as a case study. Campylobacter infections are found worldwide and are the most common bacterial food-borne disease in developed countries, where they exhibit consistent but country specific seasonality. We developed a novel conditional incidence method, based on classical stratification, exploiting the long term, high-resolution, linkage of approximately one-million campylobacteriosis cases over 20 years in England and Wales with local meteorological datasets from diagnostic laboratory locations. The predicted incidence of campylobacteriosis increased by 1 case per million people for every 5° (Celsius) increase in temperature within the range of 8° − 15°. Limited association was observed outside that range. There were strong associations with day-length. Cases tended to increase with relative humidity in the region of 75 − 80%, while the associations with rainfall and wind-speed were weaker. The approach is able to examine multiple factors and model how complex trends arise, e.g. the consistent steep increase in campylobacteriosis in England and Wales in May-June and its spatial variability. This transparent and straightforward approach leads to accurate predictions without relying on regression models and/or postulating specific parameterisations. A key output of the analysis is a thoroughly phenomenological description of the incidence of the disease conditional on specific local weather factors. The study can be crucially important to infer the elusive mechanism of transmission of campylobacteriosis; for instance, by simulating the conditional incidence for a postulated mechanism and compare it with the phenomenological patterns as benchmark. The findings challenge the assumption, commonly made in statistical models, that the transformed mean rate of infection for diseases like campylobacteriosis is a mere additive and combination of the environmental variables.
The accelerating rate of global climate and environmental changes is expected to affect the distribution, frequency, and patterns of established infectious diseases, as well as the emergence and re-emergence of both new and known diseases. Salmonella is a leading cause of foodborne illnesses in Europe, accounting for nearly one in three foodborne outbreaks. The seasonal pattern observed in cases of human salmonellosis reported suggests that weather may be a relevant driver of disease. Many studies show associations of salmonellosis with weather factors, but the exact extent of this influence is still unclear. Elucidating how the disease depends on relevant weather factors provides insights into the underlying mechanisms of transmission and provides a tool to anticipate the risk when relevant weather factors are known. This study provides new insights into the relationship between weather factors and the occurrence of salmonellosis, addressing a crucial issue in the context of climate change. By utilizing long-term, high-resolution epidemiological data from England and Wales linked with local weather data, the study offers a comprehensive phenomenological description of specific weather conditions that are related the incidence of salmonellosis. Unlike previous studies that often rely on regression models or predefined parameterizations, the methodology used in this study employs a transparent and straightforward approach to estimate disease incidence based on a wide range of 14 local weather factors linked to individual cases. A key contribution of this study is its ability to account for the simultaneous effect of up to three weather factors, providing a more holistic understanding of their combined impact on disease incidence. Air temperature (>10⁰C), relative humidity, precipitation (dry conditions), dewpoint temperature (7-10⁰C), and day length (12-15h) were identified as key weather factors associated with salmonellosis, irrespective of geographical location. These findings were validated both in England and Wales and the Netherlands, which encourages the application of the model in other regions with different climatic and social characteristics to gain new insights on the incidence of salmonellosis. Likewise, the methodology can be adapted to explore other environmental factors, such as land use, proximity to animal farms, or socio-economic factors, providing a more holistic understanding of disease dynamics. The methodology used in this study, the conditional incidence, provides a robust framework to select key weather factors and exclude less relevant ones and to better understand climate-sensitive diseases and their response to climate changes. Early warning systems enhanced with weather data can improve incidence patterns predictions and tailor interventions to specific geographic areas.
Background Human, animal, and environmental health are increasingly threatened by the emergence and spread of antibiotic resistance. Inappropriate use of antibiotic treatments commonly contributes to this threat, but it is also becoming apparent that multiple, interconnected environmental factors can play a significant role. Thus, a One Health approach is required for a comprehensive understanding of the environmental dimensions of antibiotic resistance and inform science-based decisions and actions. The broad and multidisciplinary nature of the problem poses several open questions drawing upon a wide heterogeneous range of studies. Objective This study seeks to collect and catalogue the evidence of the potential effects of environmental factors on the abundance or detection of antibiotic resistance determinants in the outdoor environment, i.e., antibiotic resistant bacteria and mobile genetic elements carrying antibiotic resistance genes, and the effect on those caused by local environmental conditions of either natural or anthropogenic origin. Methods Here, we describe the protocol for a systematic evidence map to address this, which will be performed in adherence to best practice guidelines. We will search the literature from 1990 to present, using the following electronic databases: MEDLINE, Embase, and the Web of Science Core Collection as well as the grey literature. We shall include full-text, scientific articles published in English. Reviewers will work in pairs to screen title, abstract and keywords first and then full-text documents. Data extraction will adhere to a code book purposely designed. Risk of bias assessment will not be conducted as part of this SEM. We will combine tables, graphs, and other suitable visualisation techniques to compile a database i) of studies investigating the factors associated with the prevalence of antibiotic resistance in the environment and ii) map the distribution, network, cross-disciplinarity, impact and trends in the literature.
We used Campylobacter data collected by UK Health Security Agency (UKHSA, formerly Public Health England) through national surveillance in England and Wales between 1 January 1989 and 14 April 2010 (Secondary Generation Surveillance System database). The 994,791 reported cases were linked to local weather parameters provided by the Met Office statistically interpolated to the locations of diagnostic laboratories via the MEDMI platform (Fleming LE, et al. doi:10.3390/ijerph110201725). Weather variables were available for the same period. Known travel-related cases were excluded from the analysis. The linkage was conducted on laboratory address because this was more complete than the patient residential address and the discrepancies between some weather variables (temperature and rainfall) between the laboratory and the corresponding patient location are known to be small (Nichols GL, et al. doi:10.1136/bmjopen-2012-001179; Djennad A et al doi:10.1186/s12879-018-3106-9). Daily variables available for the same time period for England and Wales included: maximum and minimum air temperature, rainfall, relative humidity and mean wind speed. Data were extracted for the date when specimen reached any of the 416 UKHSA diagnostic laboratories in England and Wales (although the data shows that only 213 laboratories were used for diagnostic) and for at least any previous 365 days; day-length was calculated from the day of the year, and the latitude of the laboratories.
Public health practitioners require measures to evaluate how vulnerable populations are to diseases, especially for zoonoses (i.e. diseases transmitted from animals to humans) given their pandemic potential. These measures would be valuable to support strategic and operational decision making and allocation of resources. But, vulnerability is well defined for natural hazards, for public health threats the concept remains undetermined. Here, we developed new methodologies to: (i) quantify the impact of zoonotic diseases and the capacity of countries to cope with these diseases, and (ii) combine these two measures (impact and capacity) into one overall vulnerability indicator. The adaptive capacity is calculated from estimations of disease mortality although the method can be adapted for diseases with no or low mortality but high morbidity. As example, we focused on the vulnerability of Nigeria and Sierra Leone to Lassa Fever and Ebola. We developed a simple analytical form that can be used to estimate vulnerability scores for different spatial units of interest, e.g. countries or regions. We showed how some populations can be highly vulnerable despite low impact threats. We finally outlined future research to more comprehensively inform vulnerability with the incorporation of relevant factors depicting local heterogeneities (e.g. bio-physical and socio-economic factors).
Poster to present the devised mechanistic model to describe the temporal dynamics of microbial communities. The main goal was to predict community stability in response to time-varying external perturbations, e.g. antibiotic treatment, and to identify the conditions under which significant shifts in their composition occur. This poster is an output of the OHEJP FED-AMR project.
Background Feline blood transfusion is required for the treatment of various illnesses in cats, and the safety of donor cats is vital. Donor adverse reactions can include cardiorespiratory, venepuncture-related, and behavioral abnormalities. Hypothesis/Objectives To describe a large number of feline blood donation events and document use of sedation and anxiolysis, record volume of blood collected and describe the frequency, type, and risk factors for, adverse reactions. Animals The study included 7812 individual cats and 29 201 donation events at a blood banking center over 5 years. Methods Retrospective analysis of donation event records with signalment, donation volume, sedation status, donation number, and adverse reactions (acute and caregiver reported) recorded. Risk factors for adverse reactions were examined by stratifying data according to groups exposed to relevant predictors and calculating odds ratios with 95% and 99% confidence intervals (CIs). Results Adverse reactions were uncommon (0.29%, 2.88/1000 donor events) and most commonly were cardiorespiratory (0.08%, 0.75/1000 donor events) or behavioral (0.06%, 0.62/1000 donor events). The only risk factor significantly associated with adverse reactions was conscious donation, with conscious donors 4.4 times more likely to have an adverse reaction (95% CI, 2.5-7.9, P ≤ .0001). Conclusions and Clinical Importance Feline blood donation is associated with a low rate of adverse reactions. Sedation should be considered to reduce adverse reactions, and the environment and interactions optimized to reduce donor stress. Caregiver education on care postdonation could reduce behavioral adverse reactions.
This paper argues for an integrative modelling approach for understanding zoonoses disease dynamics, combining process, pattern and participatory models. Each type of modelling provides important insights, but all are limited. Combining these in a ‘3P’ approach offers the opportunity for a productive conversation between modelling efforts, contributing to a ‘One Health’ agenda. The aim is not to come up with a composite model, but seek synergies between perspectives, encouraging cross-disciplinary interactions. We illustrate our argument with cases from Africa, and in particular from our work on Ebola virus and Lassa fever virus. Combining process-based compartmental models with macroecological data offers a spatial perspective on potential disease impacts. However, without insights from the ground, the ‘black box’ of transmission dynamics, so crucial to model assumptions, may not be fully understood. We show how participatory modelling and ethnographic research of Ebola and Lassa fever can reveal social roles, unsafe practices, mobility and movement and temporal changes in livelihoods. Together with longer-term dynamics of change in societies and ecologies, all can be important in explaining disease transmission, and provide important complementary insights to other modelling efforts. An integrative modelling approach therefore can offer help to improve disease control efforts and public health responses.
Rice’s theory for the statistical properties of random noise currents has been employed in the context of concentration fluctuations in dispersing plumes. Within this context, the theory has been extended to calculate the distribution of excursion times above a small threshold for arbitrary spacings between an up-crossing and the successive down-crossing. This approach has then been applied to a second-order stochastic model for the evolution of odour concentrations and their time derivative (simple model), and to the superstatistics extension of this model [Reynolds (2007) Phys. Fluids]. In agreement with the measurements of Yee and coworkers [Yee et al. (1993) Boundary-Layer Meteorol. 65, Yee et al. (1994) J. Appl. Meteorol. 33 ], both formulations predict a distribution of excursion times that can be well approximated by a power-law profile with exponent close to −3/2. For the superstatistical model the power-law profile extends over approximately three or more decades, for the simple model this range is smaller. Compared to the simple model, predictions for the superstatistical model are in a better agreement with the measurements.
Cystic echinococcosis (CE) is a zoonotic disease of global relevance that leads to significant morbidity and economic losses in the livestock industry. Effective intervention and surveillance strategies are essential and available for controlling and preventing the spread of this disease. As a Neglected Tropical Disease (NTD), one of the main obstacles of control and surveillance is resource constraints and lack of sustainable investments. The Modelling Approaches for Cystic Echinococcosis (MACE) project aims to address these issues by utilizing an interdisciplinary approach that combines spatial analysis, individual-based transmission modelling, and stakeholder elicitation techniques.
The Natal multimammate mouse (Mastomys natalensis) is the reservoir host of Lassa virus (LASV), an arenavirus that causes Lassa haemorrhagic fever in humans in West Africa. While previous studies suggest that spillover risk is focal within rural villages due to the spatial behaviour of the rodents, the level of clustering was never specifically assessed. Nevertheless, detailed information on the spatial distribution of infected rodents would be highly valuable to optimize LASV-control campaigns, which are limited to rodent control or interrupting human–rodent contact considering that a human vaccine is not available. Here, we analysed data from a four-year field experiment to investigate whether LASV-infected rodents cluster in households in six rural villages in Guinea. Our analyses were based on the infection status (antibody or PCR) and geolocation of rodents (n = 864), and complemented with a phylogenetic analysis of LASV sequences (n = 119). We observed that the majority of infected rodents were trapped in a few houses (20%) and most houses were rodent-free at a specific point in time (60%). We also found that LASV strains circulating in a specific village were polyphyletic with respect to neighbouring villages, although most strains grouped together at the sub-village level and persisted over time. In conclusion, our results suggest that: (i) LASV spillover risk is heterogeneously distributed within villages in Guinea; (ii) viral elimination in one particular village is unlikely if rodents are not controlled in neighbouring villages. Such spatial information should be incorporated into eco-epidemiological models that assess the cost-efficiency of LASV control strategies.
Comprehension of the nature and practice of science and its social context are important aspects of communicating and learning science. However there is still very little understanding amongt the non-scientific community of the need for debate in driving scientific knowledge forward and the role of critical scrutiny in quality control. Peer review is an essential part of this process. We initiated and developed a pilot project to provide an opportunity for students to explore the idea that science is a dynamic process rather than a static body of facts. Students from two different schools experienced the process of peer-review by producing and reviewing comics related to the science done at Rothamsted Research. As authors, students showed a large degree of creativity and understanding of the science while as referees they showed good critical skills. Students had at first hand an insight into how science works.
Involving and engaging the public is crucial for effective prioritisation, dissemination and implementation of research about the complex interactions between environments and health. Involvement is also important to funders and policy makers who often see it as vital for building trust and justifying the investment of public money. In public health research, 'the public' can seem an amorphous target for researchers to engage with, and the short-term nature of research projects can be a challenge. Technocratic and pedagogical approaches have frequently met with resistance, so public involvement needs to be seen in the context of a history which includes contested truths, power inequalities and political activism. It is therefore vital for researchers and policy makers, as well as public contributors, to share best practice, and to explore the challenges encountered in public involvement and engagement. This paper presents a theoretically informed case study of the contributions made by the Health and Environment Public Engagement Group (HEPE) to the work of the National Institute for Health Research Health Protection Research Unit in Environmental Change and Health (HPRU-ECH). We describe how HEPE has provided researchers in the HPRU-ECH with a vehicle to support access to public views on multiple aspects of the research work across three workshops, discussion of ongoing research issues at meetings and supporting dissemination to local government partners, as well as public representation on the HPRU-ECH Advisory Board. We conclude that institutional support for standing public involvement groups can provide conduits for connecting publics with policy makers and academic institutions. This can enable public involvement and engagement which would be difficult, if not impossible, to achieve in individual short term and unconnected research projects.
Increasing the durability of crop resistance to plant pathogens is one of the key goals of virulence management. Despite the recognition of the importance of demographic and environmental stochasticity on the dynamics of an epidemic, their effects on the evolution of the pathogen and durability of resistance has not received attention. We formulated a stochastic epidemiological model, based on the Kramer-Moyal expansion of the Master Equation, to investigate how random fluctuations affect the dynamics of an epidemic and how these effects feed through to the evolution of the pathogen and durability of resistance. We focused on two hypotheses: firstly, a previous deterministic model has suggested that the effect of cropping ratio (the proportion of land area occupied by the resistant crop) on the durability of crop resistance is negligible. Increasing the cropping ratio increases the area of uninfected host, but the resistance is more rapidly broken; these two effects counteract each other. We tested the hypothesis that similar counteracting effects would occur when we take account of demographic stochasticity, but found that the durability does depend on the cropping ratio. Secondly, we tested whether a superimposed external source of stochasticity (for example due to environmental variation or to intermittent fungicide application) interacts with the intrinsic demographic fluctuations and how such interaction affects the durability of resistance. We show that in the pathosystem considered here, in general large stochastic fluctuations in epidemics enhance extinction of the pathogen. This is more likely to occur at large cropping ratios and for particular frequencies of the periodic external perturbation (stochastic resonance). The results suggest possible disease control practises by exploiting the natural sources of stochasticity.
Numerical simulations for a non-isothermal ribbed channel flow are made. Due to the relatively low Reynolds number (Re = 14,200, based on the channel height), the results have relevance to higher Reynolds number electronics cooling systems. Through considering a k–l based zonal large Eddy simulation (ZLES) method and the S–A based detached Eddy simulation (DES) approach, the predictive accuracy of hybrid methods is assessed. This is assisted through comparisons with Reynolds-averaged Navier–Stokes (RANS) model results and also measurements. The RANS models used are the zonal k–l/EASM (explicit algebraic stress model) and k–l/cubic (non-linear cubic). The k–l modelling in these is just used near walls. Comparison reveals that both ZLES and DES are capable of capturing complex unsteady flow features associated with flow separation and reattachment. In general, for the present case, ZLES and DES perform similarly and are in better agreement with measurements than results from the zonal RANS. ZLES and DES heat transfer predictions are encouraging, the model sensitivity of results displayed when using RANS approaches being much less marked.
Recent outbreaks of animal-borne emerging infectious diseases have likely been precipitated by a complex interplay of changing ecological, epidemiological and socio-economic factors. Here, we develop modelling methods that capture elements of each of these factors, to predict the risk of Ebola virus disease (EVD) across time and space. Our modelling results match previously-observed outbreak patterns with high accuracy, and suggest further outbreaks could occur across most of West and Central Africa. Trends in the underlying drivers of EVD risk suggest a 1.75 to 3.2-fold increase in the endemic rate of animal-human viral spill-overs in Africa by 2070, given current modes of healthcare intervention. Future global change scenarios with higher human population growth and lower rates of socio-economic development yield a fourfold higher likelihood of epidemics occurring as a result of spill-over events. Our modelling framework can be used to target interventions designed to reduce epidemic risk for many zoonotic diseases.
The introduction of pasteurization, antibiotics, and vaccinations, as well as improved sanitation, hygiene, and education, were critical in reducing the burden of infectious diseases and associated mortality during the 19th and 20th centuries and were driven by an improved understanding of disease transmission. This advance has led to longer average lifespans and the expectation that, at least in the developed world, infectious diseases were a problem of the past. Unfortunately this is not the case; infectious diseases still have a significant impact on morbidity and mortality worldwide. Moreover, the world is witnessing the emergence of new pathogens, the reemergence of old ones, and the spread of antibiotic resistance. Furthermore, effective control of infectious diseases is challenged by many factors, including natural disasters, extreme weather, poverty, international trade and travel, mass and seasonal migration, rural–urban encroachment, human demographics and behavior, deforestation and replacement with farming, and climate change.
Infectious diseases attributable to unsafe water supply, sanitation and hygiene (e.g. Cholera, Leptospirosis, Giardiasis) remain an important cause of morbidity and mortality, especially in low-income countries. Climate and weather factors are known to affect the transmission and distribution of infectious diseases and statistical and mathematical modelling are continuously developing to investigate the impact of weather and climate on water-associated diseases. There have been little critical analyses of the methodological approaches. Our objective is to review and summarize statistical and modelling methods used to investigate the effects of weather and climate on infectious diseases associated with water, in order to identify limitations and knowledge gaps in developing of new methods. We conducted a systematic review of English-language papers published from 2000 to 2015. Search terms included concepts related to water-associated diseases, weather and climate, statistical, epidemiological and modelling methods. We found 102 full text papers that met our criteria and were included in the analysis. The most commonly used methods were grouped in two clusters: process-based models (PBM) and time series and spatial epidemiology (TS-SE). In general, PBM methods were employed when the bio-physical mechanism of the pathogen under study was relatively well known (e.g. Vibrio cholerae); TS-SE tended to be used when the specific environmental mechanisms were unclear (e.g. Campylobacter). Important data and methodological challenges emerged, with implications for surveillance and control of water-associated infections. The most common limitations comprised: non-inclusion of key factors (e.g. biological mechanism, demographic heterogeneity, human behavior), reporting bias, poor data quality, and collinearity in exposures. Furthermore, the methods often did not distinguish among the multiple sources of time-lags (e.g. patient physiology, reporting bias, healthcare access) between environmental drivers/exposures and disease detection. Key areas of future research include: disentangling the complex effects of weather/climate on each exposure-health outcome pathway (e.g. person-to-person vs environment-to-person), and linking weather data to individual cases longitudinally.
An amendment to this paper has been published and can be accessed via a link at the top of the paper.
Background: Campylobacteriosis is a major public health concern. The weather factors that influence spatial and seasonal distributions are not fully understood. Methods: To investigate the impacts of temperature and rainfall on Campylobacter infections in England and Wales, cases of Campylobacter were linked to local temperature and rainfall at laboratory postcodes in the 30 days before the specimen date. Methods for investigation included a comparative conditional incidence, wavelet, clustering, and time series analyses. Results: The increase of Campylobacter infections in the late spring was significantly linked to temperature two weeks before, with an increase in conditional incidence of 0.175 cases per 100,000 per week for weeks 17 to 24; the relationship to temperature was not linear. Generalized structural time series model revealed that changes in temperature accounted for 33.3% of the expected cases of Campylobacteriosis, with an indication of the direction and relevant temperature range. Wavelet analysis showed a strong annual cycle with additional harmonics at four and six months. Cluster analysis showed three clusters of seasonality with geographic similarities representing metropolitan, rural, and other areas. Conclusions: The association of Campylobacteriosis with temperature is likely to be indirect. High-resolution spatial temporal linkage of weather parameters and cases is important in improving weather associations with infectious diseases. The primary driver of Campylobacter incidence remains to be determined; other avenues, such as insect contamination of chicken flocks through poor biosecurity should be explored.
Disease resistance genes are valuable natural resources which should be deployed in a way which maximises the gain to crop productivity before they lose efficacy. Here we present a general epidemiological model for plant diseases, formulated to study the evolution of phenotypic traits of plant pathogens in response to host resistance. The model was used to analyse how the characteristics of the disease resistance, and the method of deployment, affect the size and duration of the gain. The gain obtained from growing a resistant cultivar, compared to a susceptible cultivar, was quantified as the increase in green canopy area resulting from control of foliar disease, integrated over many years—termed ‘Healthy Area Duration (HAD) Gain’. Previous work has suggested that the effect of crop ratio (the proportion of land area occupied by the resistant crop) on the gain from qualitative (gene-for-gene) resistance is negligible. Increasing the crop ratio increases the area of uninfected host, but the resistance is more rapidly broken; these two effects counteract each other. We tested the hypothesis that similar counteracting effects would occur for quantitative, multi-genic resistance, but found that the HAD Gain increased at higher crop ratios. Then we tested the hypothesis that the gain from quantitative host resistance could differ depending on the life-cycle component (sporulation rate or infection efficiency) constrained by the resistance. For the patho-system considered, a quantitative resistant cultivar that reduced the infection efficiency gave a greater HAD Gain than a cultivar that reduced sporulation rate, despite having equivalent transmission rates.
The recognition that infectious diseases can potentially increase with changes in the climate dates back to the 1990s (1, 2). Climate change is and will continue to affect infectious diseases through diverse and often overlapping ecological, biological and social mechanisms. The effect of climatic factors on infectious disease is complex. Climate influences ecological factors, such as the natural environment in which infectious agents live, grow and multiply. Climatic and ecological factors will affect organisms’ biology (for example, survival, proliferation, serotype fitness), which may lead to altered pathogen geographical ranges and distributions or the seasonality of individual pathogens. For example, there may be longer transmission periods associated with warmer conditions, although colder conditions drive people indoors, which can also increase the transmission of some respiratory infections during winter. In addition, the emergence of novel species may be influenced. Climate change may also affect transmission through impacts on key vectors, such as rodents, changes of impacts on farming and food production practices or important pathogen transport mechanisms, such as rainfall and wind contributing to the dispersal of soil organisms and pathogens. Finally, climate change may affect human behaviour and other social determinants of infectious disease risk: for example, warmer weather resulting in changed food preparation and consumption patterns, or increasing countryside visits, in turn increasing the potential exposure to infectious disease hazards (3). In England, the economic burden from infectious diseases (including costs to the health service, labour market and to individuals) is estimated at £30 billion annually, dominated by respiratory and gastrointestinal infections (4). Hence any changes to disease burdens will not only have public health implications, but also economic impacts. Changing human behaviour and policy will play an important role in infectious disease risk, both by mitigating risk or creating new risks. For example, climate change-induced increases in foodborne disease outbreaks may lead to the development of new regulations that may in turn help to minimise health burden. Alternatively, efforts to decarbonise will have important implications for land use and agriculture (see Chapter 14), which could even increase health risks if new vector habitats (see Chapter 8 for vector-borne diseases) or transmission pathways are created (5). In future, changes to health associated with climate change in the UK will occur concurrently with 2 important trends which may influence disease risk. First, the UK population is ageing: by 2066, there are likely to be an additional 8.6 million residents aged 65 years and over, comprising 26% of the total population, with the over 85 years age group showing the fastest increase (6). The rising UK elderly population will make the population more susceptible to infections, due to lowered immunity or more frequent interactions with healthcare or living in communal settings, where for example, the potential for person-to-person transmission is elevated. Second, antimicrobial resistance (AMR) poses a growing threat to human, animal and environmental health, implying that future impacts may be greater, with 10 million deaths globally predicted to occur annually by 2050 due to AMR (7). There is emerging evidence suggesting that AMR may be influenced by climate change: warming temperatures may accelerate bacterial growth, increase bacterial infection rates, increase the frequency of infections in healthcare settings and expand geographical distributions (8 to 12). These processes increase the likelihood of horizontal gene transfer and thus the emergence of drug-resistant infections. However, the incidence of respiratory infections is higher during winter, resulting in greater antimicrobial use for treatment, and increasing the risk of drug-resistant infections developing as a result. In addition, wastewater is a well-known reservoir for antibiotic-resistance genes, as bacteria can encounter antimicrobial effluent and develop antimicrobial resistance genes (13, 14). More frequent and intense precipitation and flooding events in future will likely lead to increased agricultural runoff and pollutants in water, causing bacterial blooms and further opportunities for antibiotic resistant gene transfer (14, 15). Though details on AMR and effects on specific pathogenic species are out of the scope of this chapter, they are important to note as an emerging climate related health risk. Infectious diseases have been considered in the ‘Health Effects of Climate Change in the UK (HECC)’ reports since 2002 (16), when infectious disease was mostly covered within the ‘Food poisoning and climate change’ chapter. This chapter highlighted parts of food chains where weather may affect the risk of food poisoning (an umbrella term which includes different foodborne illnesses). In another chapter, the potential for changing ultraviolet light (UV-B) levels to affect immune suppression and virus activation were discussed, and the report briefly considered adaptation, highlighting the largely unknown capacity of the population to adapt to a changing climate. Indirect influences of climate on infectious disease, such as dietary choice and human behaviour, were briefly mentioned. Integrated assessment models were highlighted as suitable for modelling the impacts of climate change on infectious diseases. In the 2008 report, ‘food poisoning’ was separated into constituent illnesses, predominantly Salmonella and Campylobacter (17). The flooding chapter included infectious disease risks, and UK consequences of climate change impacts on global food prices was also discussed. By 2012, a wider range of infectious diseases and transmission routes were considered (18). The water and food chapters were merged, and there was greater emphasis on food as a global commodity. The impact of the built environment upon the airborne transmission of infectious diseases was explicitly addressed for the first time, and concerns about UV-B levels affecting immune suppression remained. The scarcity of data on how climate change may influence human behaviour, and hence impact disease incidence, was noted. Adaptation and resilience of the food sector to changing diseases were explicitly considered. The importance of food as a contributor to greenhouse gas (GHG) emissions was included, alongside the imperative of ensuring that food associated GHG mitigation measures do not adversely affect food safety. It highlighted the importance of dietary choice for GHG emissions and noted win-wins from dietary changes (for instance, lower animal product consumption reduces both GHG emissions and saturated fat intake). The report recommended that all climate change mitigation policies be subject to health impact assessment.
A different class of stochastic model, comprising of the Langevin equation with a random time scale, for the simulation of fluid velocities along particle trajectories in high Reynolds-number turbulent flows is formulated. These velocities are neither purely Lagrangian nor purely Eulerian in character. The distribution of time scales is chosen to ensure that the modeled form of the fluid-velocity structure function and spectral functions are compatible with Kolmogorov similarity scaling and with the scaling analysis of Fung, Hunt, and Perkins [Proc. R. Soc. London, Ser. A 459, 445 (2003)]. It is shown that the model accounts naturally for the crossing trajectory effect and integral time scales are compatible with the much used parameterizations advocated by Csanady [J. Atmos. Sci. 20, 201 (1963)] and by Frenkiel [Adv. Appl. Mech. 3, 61 (1953)]. Model predictions for particle dispersion in grid generated turbulence are shown to be in close accord with the experimental data of Snyder and Lumley [J. Fluid Mech. 48, 41 (1971)].
Understanding the emergence and subsequent spread of human infectious diseases is a critical global challenge, especially for high-impact zoonotic and vector-borne diseases. Global climate and land-use change are likely to alter host and vector distributions, but understanding the impact of these changes on the burden of infectious diseases is difficult. Here, we use a Bayesian spatial model to investigate environmental drivers of one of the most important diseases in Africa, Rift Valley fever (RVF). The model uses a hierarchical approach to determine how environmental drivers vary both spatially and seasonally, and incorporates the effects of key climatic oscillations, to produce a continental risk map of RVF in livestock (as a proxy for human RVF risk). We find RVF risk has a distinct seasonal spatial pattern influenced by climatic variation, with the majority of cases occurring in South Africa and Kenya in the first half of an El Niño year. Irrigation, rainfall and human population density were the main drivers of RVF cases, independent of seasonal, climatic or spatial variation. By accounting more subtly for the patterns in RVF data, we better determine the importance of underlying environmental drivers, and also make space- and time-sensitive predictions to better direct future surveillance resources.
Background Biting midges of the genus Culicoides Latreille, 1809 (Diptera: Ceratopogonidae) cause a significant biting nuisance to equines and are responsible for the biological transmission of African horse sickness virus (AHSV). While currently restricted in distribution to sub-Saharan Africa, AHSV has a history of emergence into southern Europe and causes one of the most lethal diseases of horses and other species of Equidae. In the event of an outbreak of AHSV, the use of insecticide treated nets (ITNs) to screen equine accomodation is recommended by competent authorities including the Office International des Épizooties (OIE) in order to reduce vector-host contact. Methods Seven commercially avaliable pyrethroid insecticides and three repellent compounds, all of which are licensed for amateur use, were assessed in modified World Health Organization (WHO) cone bioassay trials in the laboratory using a colony line of Culicoides nubeculosus (Meigen), 1830. Two field trials were subsequently conducted to test the efficiency of treated net screens in preventing entry of Culicoides. Results A formulation of cypermethrin (0.15 % w/w) and pyrethrins (0.2 % w/w) (Tri-Tec 14®, LS Sales (Farnham) Ltd, Bloxham, UK) applied to black polyvinyl-coated polyester insect screen (1.6 mm aperture; 1.6 mm thickness) inflicted 100 % mortality on batches of C. nubeculosus following a three minute exposure in the WHO cone bioassays at 1, 7 and 14 days post-treatment. Tri-Tec 14® outperformed all other treatments tested and was subsequently selected for use in field trials. The first trial demonstrated that treated screens placed around an ultraviolet light-suction trap entirely prevented Culicoides being collected, despite their collection in identical traps with untreated screening or no screening. The second field trial examined entry of Culicoides into stables containing horses and found that while the insecticide treated screens reduced entry substantially, there was still a small risk of exposure to biting. Conclusions Screened stables can be utilised as part of an integrated control program in the event of an AHSV outbreak in order to reduce vector-host contact and may also be applicable to protection of horses from Culicoides during transport.
Abstract Hepatitis A is caused by hepatitis A virus and occurs worldwide. Estimating the transmissibility, which is usually characterized by the so-called basic reproductive number R0, the mean number of secondary infectious cases generated by one primary infectious case introduced into a totally susceptible population, provides crucial information for the effort required to eliminate infection. Hepatitis A virus is usually transmitted indirectly through contaminated food and environment. An outbreak from March to June 2011 was reported to occur at an elementary school in China and it was evidenced that the outbreak is due to direct transmission between school children. Based on the data of symptom onset date and social contact network, in this study we estimate the serial interval (the gap in symptom onset between an infectors and its infector) and use different statistical methods to estimate R0.To take into account the fact that many HAV infections in children are asymptomatic, a transmission dynamics model is proposed to estimate R0. Our results suggest a serial interval of mean =23.9 days and standard deviation =20.9 days. The different statistical methods suggest that R0 in the 2011 outbreak at the elementary school in China ranges from 1.9 to 2.5, which overlap with the results from the epidemic model. Our estimates are in agreement with the estimate in England but higher than that in the United States.
Four different searching strategies to locate the source of odor in turbulent flows have been computationally tested. These algorithms can be separated into two classes. One is based on the rate of odor patches encountered by the searcher, the other employs the variation of odor concentrations as well as the rate of odor patches experienced by the searcher. The concentration of odor has been simulated by using a stochastic model for the time-evolution of concentrations along the path of a moving observer in an inhomogeneous plume. For each algorithm, we released the searchers at a crosswind location away from the plume centerline; we then calculated the ensemble average position relative to the plume centerline and the distribution of the searchers along the crosswind direction at the source. Compared with strategies using rate of odor patches only, the algorithms that also employ the variation of concentrations are seen to be more effective in locating the source; that is, the average path of all searchers is more biased toward the plume centerline and their crosswind distribution is more skewed toward the source. The findings of this work can be used as guidelines to discriminate successful strategies that can be tested in future experiments.
Predictions for the number of particles depositing from fully developed turbulence onto a fully roughened kk-type surface are obtained from the results of large-eddy simulations for a ribbed-channel flow. Simulation data are found to provide only partial support for the “mass-sink hypothesis,” i.e., the notion that all particles entering a mass sink, a volume of fluid extending vertically from the deposition surface, are captured and eventually deposited. The equality of the number of particles entering the mass sink and the number of particles depositing is attained, and a qualitative agreement with the empirical model of Wood (1981, “A Simple Method for the Calculation of Turbulent Deposition to Smooth and Rough Surfaces ,” J. Aerosol Sci., 12(3), pp. 275–290) for the height of this mass sink is obtained. However, a significant proportion of particles escapes from the mass sink and the equality of numbers is attained only because many particles deposit onto rib surfaces above the mass sink, without first entering the mass sink.
We develop a stochastic model for the time-evolution of scalar concentrations and temporal gradients in concentration experienced by observers moving within inhomogeneous plumes that are dispersing within turbulent flows. In this model, scalar concentrations and their gradients evolve jointly as a Markovian process. Underlying the model formulation is a natural generalisation of Thomson’s well mixed condition [Thomson DJ (1987) J Fluid Mech 180:529–556]. As a consequence model outputs are necessarily compatible with statistical properties of scalars observed in experiment that are used here as model input. We then use the model to examine how insects aloft within the atmospheric boundary-layer can locate odour sources by modulating their flight patterns in response to odour cues. Mechanisms underlying odour-mediated flights have been studied extensively at laboratory-scale but an understanding of these flights over landscape scales is still lacking. Insect flights are simulated by combining the stochastic model with a simple model of insect olfactory response. These simulations show the strong influence of wind speed on the distributions of the times taken by insects to locate the source. In accordance with experimental observations [Baker TC, Vickers NJ (1997) In: Insect pheromone research: new directions, pp 248–264; Mafra-Neto A, Cardé RT (1994) Nature 369:142–144], flight patterns are predicted to become straighter and shorter, and source location is predicted to become more likely as the mean wind speed increases. The most probable arrival time to the source decreases with the mean wind speed. It is shown that scale-free movement patterns arising from olfactory-driven foraging stem directly from the power-law distribution of concentration excursion times above/below a threshold level and are robust with respect to variations in Reynolds number. Flight lengths are well represented by a power law distribution in agreement with the observed patterns of foraging bumblebees [Heinrich B (1979) Oecologia 40(3):235–245].
A Lagrangian stochastic model has been formulated to simulate the dispersion of Brownian (submicron-sized) particles in turbulent flows and their deposition onto adjacent flow boundaries. The model is applied to the prediction of Brownian-particle dispersion and deposition under non-isothermal conditions. Thermophoresis is shown to arise naturally from the modelling approach which is based upon a natural extension of Thomson's (1987, Journal of Fluid Mechanics, 180, 529–556) well-mixed condition. In accordance with results present in the literature, it is found that thermophoresis has a significant impact upon model predictions for the deposition of Brownian particles from fully developed turbulence onto hydraulically smooth surfaces.
The gut microbiota play a key role in the health of animals and humans. However, the dynamic properties and stability of the microbiota are poorly understood. We propose a regression technique for parameter inference of a mechanistic model to describe the temporal dynamics of these microbial communities. The model could be used for measuring community resilience against external perturbing factors, such as antibiotic therapy.
Vector-borne diseases represent complex infection transmission systems; previous epidemiological models have been unable to formally capture the relationship between the ecological limits of vector species and the dynamics of pathogen transmission. By making this advance for the key disease, Rift Valley fever, we are able to show how seasonally varying availability of water bodies and ambient temperatures dictate when the mosquito vector populations will persist and importantly, those sets of conditions resulting in stable oscillations of disease transmission. Importantly, under the latter scenario, short-term health control measures will likely fail, as the system quickly returns to the original configuration after the intervention stops. Our model, therefore, offers an important tool to better understand vector-borne diseases and design effective eradication programs.
Background Zoonotic infections, which transmit from animals to humans, form the majority of new human pathogens. Following zoonotic transmission, the pathogen may already have, or may acquire, the ability to transmit from human to human. With infections such as Lassa fever (LF), an often fatal, rodent-borne, hemorrhagic fever common in areas of West Africa, rodent-to-rodent, rodent-to-human, human-to-human and even human-to-rodent transmission patterns are possible. Indeed, large hospital-related outbreaks have been reported. Estimating the proportion of transmission due to human-to-human routes and related patterns (e.g. existence of super-spreaders), in these scenarios is challenging, but essential for planned interventions. Methodology/Principal Findings Here, we make use of an innovative modeling approach to analyze data from published outbreaks and the number of LF hospitalized patients to Kenema Government Hospital in Sierra Leone to estimate the likely contribution of human-to-human transmission. The analyses show that almost of the cases at KGH are secondary cases arising from human-to-human transmission. However, we found much of this transmission is associated with a disproportionally large impact of a few individuals (‘super-spreaders’), as we found only of human cases result in an effective reproduction number (i.e. the average number of secondary cases per infectious case) , with a maximum value up to . Conclusions/Significance This work explains the discrepancy between the sizes of reported LF outbreaks and a clinical perception that human-to-human transmission is low. Future assessment of risks of LF and infection control guidelines should take into account the potentially large impact of super-spreaders in human-to-human transmission. Our work highlights several neglected topics in LF research, the occurrence and nature of super-spreading events and aspects of social behavior in transmission and detection.
A considerable amount of disease is transmitted from animals to humans and many of these zoonoses are neglected tropical diseases. As outbreaks of SARS, avian influenza and Ebola have demonstrated, however, zoonotic diseases are serious threats to global public health and are not just problems confined to remote regions. There are two fundamental, and poorly studied, stages of zoonotic disease emergence: ‘spillover’, i.e. transmission of pathogens from animals to humans, and ‘stuttering transmission’, i.e. when limited human-to-human infections occur, leading to self-limiting chains of transmission. We developed a transparent, theoretical framework, based on a generalization of Poisson processes with memory of past human infections, that unifies these stages. Once we have quantified pathogen dynamics in the reservoir, with some knowledge of the mechanism of contact, the approach provides a tool to estimate the likelihood of spillover events. Comparisons with independent agent-based models demonstrates the ability of the framework to correctly estimate the relative contributions of human-to-human vs animal transmission. As an illustrative example, we applied our model to Lassa fever, a rodent-borne, viral haemorrhagic disease common in West Africa, for which data on human outbreaks were available. The approach developed here is general and applicable to a range of zoonoses. This kind of methodology is of crucial importance for the scientific, medical and public health communities working at the interface between animal and human diseases to assess the risk associated with the disease and to plan intervention and appropriate control measures. The Lassa case study revealed important knowledge gaps, and opportunities, arising from limited knowledge of the temporal patterns in reporting, abundance of and infection prevalence in, the host reservoir.
Background: To understand the impact of weather on infectious diseases, information on weather parameters at patient locations is needed, but this is not always accessible due to confidentiality or data availability. Weather parameters at nearby locations are often used as a proxy, but the accuracy of this practice is not known. Methods: Daily Campylobacter and Cryptosporidium cases across England and Wales were linked to local temperature and rainfall at the residence postcodes of the patients and at the corresponding postcodes of the laboratory where the patient’s specimen was tested. The paired values of daily rainfall and temperature for the laboratory versus residence postcodes were interpolated from weather station data, and the results were analysed for agreement using linear regression. We also assessed potential dependency of the findings on the relative geographic distance between the patient’s residence and the laboratory. Results: There was significant and strong agreement between the daily values of rainfall and temperature at diagnostic laboratories with the values at the patient residence postcodes for samples containing the pathogens Campylobacter or Cryptosporidium. For rainfall, the R-squared was 0.96 for the former and 0.97 for the latter, and for maximum daily temperature, the R-squared was 0.99 for both. The overall mean distance between the patient residence and the laboratory was 11.9 km; however, the distribution of these distances exhibited a heavy tail, with some rare situations where the distance between the patient residence and the laboratory was larger than 500 km. These large distances impact the distributions of the weather variable discrepancies (i.e. the differences between weather parameters estimated at patient residence postcodes and those at laboratory postcodes), with discrepancies up to ±10 °C for the minimum and maximum temperature and 20 mm for rainfall. Nevertheless, the distributions of discrepancies (estimated separately for minimum and maximum temperature and rainfall), based on the cases where the distance between the patient residence and the laboratory was within 20 km, still exhibited tails somewhat longer than the corresponding exponential fits suggesting modest small scale variations in temperature and rainfall. Conclusion: The findings confirm that, for the purposes of studying the relationships between meteorological variables and infectious diseases using data based on laboratory postcodes, the weather results are sufficiently similar to justify the use of laboratory postcode as a surrogate for domestic postcode. Exclusion of the small percentage of cases where there is a large distance between the residence and the laboratory could increase the precision of estimates, but there are generally strong associations between daily weather parameters at residence and laboratory.
Understanding the influence of non-susceptible hosts on vector-borne disease transmission is an important epidemiological problem. However, investigation of its impact can be complicated by uncertainty in the location of the hosts. Estimating the risk of transmission of African horse sickness (AHS) in Great Britain (GB), a virus transmitted by Culicoides biting midges, provides an insightful example because: (i) the patterns of risk are expected to be influenced by the presence of non-susceptible vertebrate hosts (cattle and sheep) and (ii) incomplete information on the spatial distribution of horses is available because the GB National Equine Database records owner, rather than horse, locations. Here, we combine land-use data with available horse owner distributions and, using a Bayesian approach, infer a realistic distribution for the location of horses. We estimate the risk of an outbreak of AHS in GB, using the basic reproduction number (R0), and demonstrate that mapping owner addresses as a proxy for horse location significantly underestimates the risk. We clarify the role of non-susceptible vertebrate hosts by showing that the risk of disease in the presence of many hosts (susceptible and non-susceptible) can be ultimately reduced to two fundamental factors: first, the abundance of vectors and how this depends on host density, and, second, the differential feeding preference of vectors among animal species.
Summary Reasons for performing the study The National Equine Database (NED) contains information on the size and distribution of the horse population, but the data quality remains unknown. These data could assist with surveillance, research and contingency planning for equine infectious disease outbreaks. Objectives 1) To assess the extent of obsolete and missing data from NED, 2) evaluate the extent of spatial separation between horse and owner location and 3) identify relationships between spatial separation and land use. Methods Two questionnaires were used to assess data accuracy in NED utilising local authority passport inspections and distribution of questionnaires to 11,000 horse owners. A subset of 1010 questionnaires was used to assess horse–owner geographic separation. Results During 2005–2010, 17,048 passports were checked through local authority inspections. Of these, 1558 passports (9.1%; 95% confidence interval [CI] 8.7–9.5%) were noncompliant, with 963 (5.6%; 95% CI 5.3–6.0%) containing inaccurate information and 595 (3.5%; 95% CI 3.2–3.8%) classified as missing. Of 1382 questionnaires completed by horse owners, 380 passports were obsolete (27.5%; 95% CI 25.2–29.9%), with 162 (11.7%; 95% CI 10.0–13.4%) being retained for deceased horses and 218 (15.8%; 95% CI 13.9–17.7%) having incorrect ownership details. Fifty-three per cent (95% CI 49.9–56.1%) of owners kept their horse(s) at home and 92% (95% CI 90.3–93.7%) of horses resided within 10 km of their owners. Conclusions and potential relevance Data from a small sample survey suggest the majority of data on NED are accurate but a proportion of inaccuracies exist that may cause delay in locating horses and contacting owners during a disease outbreak. The probability that horses are located in the same postcode sector as the owner's home address is larger in rural areas. Appropriate adjustment for population size, horse–owner spatial separation and land usage would facilitate meaningful use of the national horse population derived from NED for risk modelling of incursions of equine diseases into Great Britain.
We show how an incorrect prediction of the t-dependence of diffractive deep inelastic scattering in the Anisotropic Chromo-Dynamics ACD framework was due to the erroneous evaluation of colour-traces through the perturbation theory Ž . prescription. By employing the ‘‘colour filtering’’ required by colour confinement, good agreement with experiment is obtained. As a result we extend our discussion to the diagrams of PQCD and we argue that submitting them to ‘‘colour filtering’’ removes their inconsistency with quark confinement and with the basic ideas of ACD.
Predictions for the deposition of spherical and cylindrical particles from a ribbed channel flow onto adjacent flow boundaries are obtained using large eddy simulation (LES) under the assumption of one-way coupling. Results indicate that spherical particles tend to accumulate on the vertical rib wall facing the mean-flow direction with little particle deposition onto surfaces immediately downstream of the rib. This preferential deposition is not predicted for cylindrical particles.
Transport and deposition of aerosol particles in a plane channel with a ribbed wall are studied in order to investigate the effects of the turbulent flow structure on particle deposition. In this paper, kinematic simulation (KS) has been adapted to be a sub-grid model for particles, in conjunction with large eddy simulation (LES) in real space with boundaries. KS is a Lagrangian model of turbulent dispersion that takes into account the effects of spatio-temporal flow structure on particle dispersion. It is a unified Lagrangian model of one-, two- and indeed multi-particle turbulent dispersion and can easily be used as a Lagrangian sub-grid model for LES codes, thus enabling complex geometry to be taken into account. To study the effect of small-scale flow structures on particle deposition in the ribbed channel flow, we use a validated LES code to simulate the flow field, and KS to model the sub-grid flow structures. Thus, the large scales are resolved by the simulation and the small scales are modelled using various sub-grid models. As none of the existing sub-grid models is known to have taken into account the effects of small-scale turbulent flow structures on particle deposition, it is important to use KS's ability to remodel the sub-grid velocity field and thereby incorporate its effect on particle deposition. The parameters of our simulations for LES are the Reynolds number, width of the channel, height of the rib and sub-gridmodel parameters. For KS, the parameters are the energy dissipation rate obtained from LES, the energy spectra, ratio of the largest and smallest sub-grid scales and the total number of modes for the sub-grid velocity field. The turbulent flow features thus obtained are compared with published experimental data in a ribbed channel. Our results suggest that while the small-scale (sub-grid) turbulent flow structures have negligible effects on particles with large relaxation times (compared with the Kolmogorov dissipation time scale), deposition of the particles with small relaxation times in the ribbed channel can be affected by these sub-grids.
This review outlines the benefits of using multiple approaches to improve model design and facilitate multidisciplinary research into infectious diseases, as well as showing and proposing practical examples of effective integration. It looks particularly at the benefits of using participatory research in conjunction with traditional modelling methods to potentially improve disease research, control and management. Integrated approaches can lead to more realistic mathematical models which in turn can assist with making policy decisions that reduce disease and benefit local people. The emergence, risk, spread and control of diseases are affected by many complex bio-physical, environmental and socio-economic factors. These include climate and environmental change, land-use variation, changes in population and people’s behaviour. The evidence base for this scoping review comes from the work of a consortium, with the aim of integrating modelling approaches traditionally used in epidemiological, ecological and development research. A total of five examples of the impacts of participatory research on the choice of model structure are presented. Example 1 focused on using participatory research as a tool to structure a model. Example 2 looks at identifying the most relevant parameters of the system. Example 3 concentrates on identifying the most relevant regime of the system (e.g., temporal stability or otherwise), Example 4 examines the feedbacks from mathematical models to guide participatory research and Example 5 goes beyond the so-far described two-way interplay between participatory and mathematical approaches to look at the integration of multiple methods and frameworks. This scoping review describes examples of best practice in the use of participatory methods, illustrating their potential to overcome disciplinary hurdles and promote multidisciplinary collaboration, with the aim of making models and their predictions more useful for decision-making and policy formulation.
Background Many infectious diseases of public health importance display annual seasonal patterns in their incidence. We aimed to systematically document the seasonality of several human infectious disease pathogens in England and Wales, highlighting those organisms that appear weather-sensitive and therefore may be influenced by climate change in the future. Methods Data on infections in England and Wales from 1989-2014 were extracted from the Public Health England (PHE) SGSS surveillance database. We conducted a weekly, monthly and quarterly time series analysis of 277 pathogen serotypes. Each organism’s time series was forecasted using the TBATS package in R, with seasonality detected using model fit statistics. Meteorological data hosted on the MEDMI Platform were extracted at a monthly resolution for 2001-2011. The organisms were then clustered by K-means into two groups based on cross correlation coefficients with the weather variables. Results Examination of 12.9 million infection episodes found seasonal components in 91/277 (33%) organism serotypes. Salmonella showed seasonal and non-seasonal serotypes. These results were visualised in an online Rshiny application. Seasonal organisms were then clustered into two groups based on their correlations with weather. Group 1 had positive correlations with temperature (max, mean and min), sunshine and vapour pressure and inverse correlations with mean wind speed, relative humidity, ground frost and air frost. Group 2 had the opposite but also slight positive correlations with rainfall (mm, >1mm, >10mm). Conclusions The detection of seasonality in pathogen time series data and the identification of relevant weather predictors can improve forecasting and public health planning. Big data analytics and online visualisation allow the relationship between pathogen incidence and weather patterns to be clarified.
Increasingly, the potential short and long-term impacts of climate change on human health and wellbeing are being demonstrated. However, other environmental change factors, particularly relating to the natural environment, need to be taken into account to understand the totality of these interactions and impacts. This paper provides an overview of ongoing research in the Health Protection Research Unit (HPRU) on Environmental Change and Health, particularly around the positive and negative effects of the natural environment on human health and well-being and primarily within a UK context. In addition to exploring the potential increasing risks to human health from water-borne and vector-borne diseases and from exposure to aeroallergens such as pollen, this paper also demonstrates the potential opportunities and co-benefits to human physical and mental health from interacting with the natural environment. The involvement of a Health and Environment Public Engagement (HEPE) group as a public forum of “critical friends” has proven useful for prioritising and exploring some of this research; such public involvement is essential to minimise public health risks and maximise the benefits which are identified from this research in environmental change and human health. Research gaps are identified and recommendations made for future research into the risks, benefits and potential opportunities of climate and other environmental change on human and planetary health.